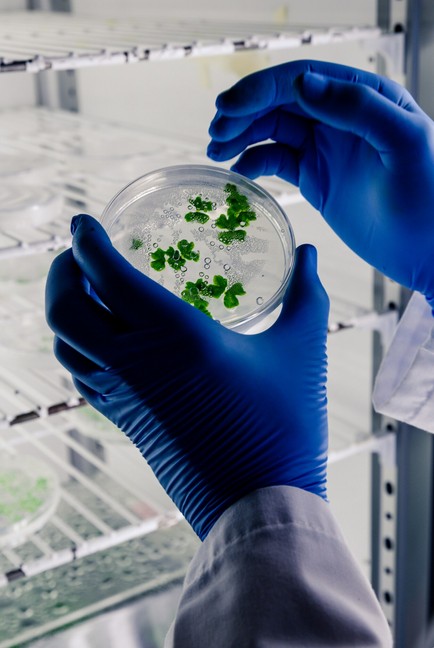

Biotech’s Global Voice: Precision Unlocked
Seamlessly expand your groundbreaking biotechnology innovations across borders with unparalleled linguistic accuracy.
Empowering global scientific exchange, our specialized biotechnology translation services ensure your critical research, clinical data, and regulatory documents resonate universally.
Global Reach: Accelerate your innovations worldwide. Our precise translations ensure your biotechnology breakthroughs transcend linguistic barriers, reaching global markets and scientific communities with unparalleled clarity and impact.
Absolute Accuracy: Navigate complex global regulations. Meticulous translation safeguards your regulatory submissions, ensuring full compliance and expedited approvals across diverse international jurisdictions, mitigating risk effectively.
Unwavering Precision: Preserve core scientific meaning. Our expert linguists, deeply versed in life sciences, guarantee that every technical nuance and scientific detail remains perfectly intact across all languages.
The Crucial Role of Biotechnology Translation in a Globalized World.
The biotechnology sector stands at the vanguard of human progress, perpetually pushing the boundaries of what is medically and scientifically conceivable. From gene therapies and novel drug discoveries to advanced diagnostics and agricultural breakthroughs, the pace of innovation is relentless. Yet, the profound impact of these advancements hinges not merely on their scientific merit but critically on their global dissemination and comprehension. This is where life science professional translation services become an indispensable conduit, transforming complex scientific discourse into universally accessible knowledge.
In an interconnected world, biotechnology companies operate within a global ecosystem. Research collaborations span continents, clinical trials involve diverse patient populations, and regulatory submissions must navigate myriad national frameworks. Each stage demands absolute linguistic precision. A minor mistranslation in a patent application could jeopardize intellectual property, an imprecise rendering of patient consent forms could invalidate clinical trial data, and inaccurate labeling could lead to catastrophic health outcomes. The stakes are extraordinarily high, making professional translation services not just a convenience, but a fundamental pillar of ethical practice, regulatory compliance, and market success.
The inherent complexity of biotechnology documentation necessitates a specialized approach. This is not merely about converting words from one language to another; it requires a profound understanding of intricate scientific concepts, highly specific terminology, and the nuanced regulatory landscapes of different jurisdictions. Translators must possess not only exceptional linguistic prowess but also deep subject-matter expertise in fields such as molecular biology, genetics, pharmacology, bioinformatics, and clinical research. Without this specialized knowledge, even the most fluent generalist translator risks misinterpreting critical data or misrepresenting scientific findings, leading to potentially dire consequences.
Furthermore, the rapid evolution of biotechnology introduces a constant influx of novel terms and concepts. Translators must remain perpetually abreast of the latest scientific breakthroughs and terminological developments to ensure their work is both accurate and current. This continuous learning, coupled with rigorous quality assurance protocols, distinguishes truly expert professional translation services in the biotechnology domain. They act as vital linguistic bridges, ensuring that groundbreaking innovations can transcend geographical and linguistic barriers, reaching the scientists, regulators, healthcare providers, and patients who stand to benefit most. Without this meticulous linguistic transfer, the potential of biotechnology would remain largely untapped on the global stage.
Unlocking Global Potential: Your Biotechnology Innovations Deserve Universal Understanding.
Bridging Linguistic Divides with Unparalleled Scientific Precision and Cultural Acumen.
Our specialized biotechnology translation services are engineered to ensure your groundbreaking research and products resonate accurately across every global market, fostering seamless international collaboration and market penetration.
Navigating Linguistic Labyrinths: Specialized Challenges in Life Science Translation.
The translation of life science content, particularly within the burgeoning field of biotechnology, presents a unique confluence of linguistic, scientific, and cultural challenges. Unlike general translation, this domain demands an almost surgical precision, where ambiguity is anathema and accuracy is paramount. One of the primary hurdles lies in the highly specialized and constantly evolving terminology. Biotechnology is replete with acronyms, neologisms, and highly technical jargon that often lack direct equivalents in other languages. Translators must navigate these lexical minefields with expert discernment, often relying on extensive glossaries, translation memories, and collaborative platforms to ensure consistency and correctness.
Beyond mere vocabulary, the conceptual density of biotechnology texts requires translators to grasp the underlying scientific principles. Translating a clinical trial protocol, for instance, involves understanding not just the words, but the methodology, statistical parameters, and ethical considerations embedded within the text. This cognitive load is immense, demanding linguists who are often scientists or medical professionals themselves, capable of interpreting complex data and conveying it accurately in the target language. The very structure of scientific writing, with its emphasis on objectivity, conciseness, and logical flow, must also be meticulously preserved across linguistic divides.
Cultural nuances introduce another layer of complexity, particularly in patient-facing materials. Informed consent forms, patient diaries, and instructional guides must be not only linguistically accurate but also culturally appropriate and easily comprehensible to diverse populations. This involves adapting tone, addressing health literacy levels, and sometimes even re-conceptualizing certain ideas to resonate effectively within a specific cultural context. For instance, direct literal translations of medical advice can be misinterpreted if cultural beliefs about health and illness are not considered.
Special Peculiarities When Translating Life Science Topics to Languages Like Arabic:
Translating complex life science and biotechnology content into Arabic presents a distinct set of challenges that underscore the need for specialized expertise. Arabic, a Semitic language, differs significantly from Indo-European languages in its grammatical structure, morphology, and script (right-to-left). This fundamental difference can lead to text expansion or contraction issues, impacting document layout and design, especially for materials like medical device labels or packaging inserts.
Furthermore, Arabic possesses a rich and varied lexicon, with numerous regional dialects. For formal, scientific, and medical texts, Modern Standard Arabic (MSA) is generally used, but even within MSA, specific scientific and medical terminology can vary, and precise equivalents for cutting-specific biotech terms may not exist or be widely standardized. Translators must be adept at coining appropriate terms or using established Arabic medical/scientific academies’ approved terminology.
Cultural and religious sensitivities are also paramount. Healthcare concepts, disease descriptions, and even visual representations in patient-facing materials must be carefully vetted to ensure they align with local cultural norms and religious beliefs. What might be acceptable imagery or phrasing in a Western context could be inappropriate or misunderstood in an Arabic-speaking country. This requires translators to possess deep cultural intelligence in addition to their linguistic and scientific expertise.
Finally, the regulatory landscape in various Arabic-speaking countries can differ significantly, requiring translators to be intimately familiar with local health authority guidelines (e.g., those in Saudi Arabia, UAE, or Egypt) to ensure compliance for drug registrations, clinical trial submissions, and medical device approvals. For comprehensive and culturally sensitive life science translations into Arabic, specialized services like those offered by eArabiTranslations.com’s life science translation services are indispensable. They possess the nuanced understanding required to navigate these intricate linguistic and cultural landscapes, ensuring that critical biotechnology information is conveyed with absolute accuracy and cultural resonance.
Oris Translations’ Unrivaled Expertise in Life Sciences: Precision, Compliance, Innovation.
In the intricate and highly regulated realm of biotechnology, the demand for professional translation services that combine scientific acumen with linguistic mastery is paramount. Oris Translations stands as a beacon of excellence in this specialized field, offering comprehensive life science professional translation services tailored to the unique exigencies of the biotech, pharmaceutical, and medical device industries. Our commitment to precision, unwavering adherence to regulatory standards, and innovative integration of human expertise with cutting-edge technology position us as the preferred partner for global life science enterprises.
What distinguishes Oris Translations is our meticulously curated team of linguists. These are not merely translators; they are subject-matter experts with advanced degrees and practical experience in diverse scientific disciplines, including molecular biology, genetics, pharmacology, clinical research, and regulatory affairs. This profound domain knowledge ensures that every translated document, from complex patent applications and intricate research papers to sensitive patient recruitment materials and critical regulatory submissions, retains its original scientific integrity and nuanced meaning. Our linguists comprehend the underlying science, allowing them to accurately convey complex concepts and highly specialized terminology, avoiding the pitfalls of literal translation that can undermine scientific validity.
Our methodology is underpinned by a rigorous, multi-tiered quality assurance process. Every project undergoes a meticulous review by a second, equally qualified linguist, followed by a final quality check to guarantee terminological consistency, grammatical accuracy, and cultural appropriateness. This stringent protocol is vital in the life sciences, where even a minor error can have profound implications for patient safety, legal compliance, or research outcomes. We leverage advanced translation memory (TM) and terminology management (TMG) tools to ensure unparalleled consistency across large volumes of documentation, reducing turnaround times and optimizing costs without compromising quality.
Oris Translations is acutely aware of the stringent regulatory frameworks governing the life sciences industry worldwide. Our processes are designed to ensure full compliance with international standards such as ISO 17100 and ISO 9001, as well as specific regulatory requirements from bodies like the FDA, EMA, and ICH. We provide certified translations for regulatory submissions, clinical trial documentation, and intellectual property filings, giving our clients the confidence that their translated materials will meet all necessary legal and scientific criteria in target markets. Our expertise extends to handling highly confidential data with robust security protocols, ensuring the utmost discretion for sensitive research and proprietary information.
For companies seeking comprehensive health care professional translation services within the biotechnology sphere, Oris Translations offers an integrated solution. This encompasses everything from preclinical study reports and clinical trial documentation to manufacturing process descriptions, product labeling, and post-market surveillance reports. Our ability to seamlessly bridge linguistic and cultural divides empowers biotech innovators to accelerate global market entry, foster international collaborations, and ultimately, bring life-changing therapies and technologies to patients around the world. Our dedication to linguistic excellence and scientific accuracy makes us an indispensable partner in the global advancement of biotechnology. For more information on our comprehensive approach to linguistic solutions, visit our professional translation services page.
Navigating Regulatory Complexities: Ensuring Flawless Compliance Across International Borders.
Meticulous Translation Safeguards Your Critical Submissions, Accelerating Global Approvals.
With an intricate understanding of global life science regulations, our certified translations guarantee that your documents meet the most stringent requirements, minimizing delays and ensuring compliance worldwide.

Future Horizons: Innovation, Accessibility, and the Evolving Role of Translation.
The biotechnology landscape is characterized by ceaseless innovation, a dynamic that profoundly influences the demands placed upon professional translation services. As breakthroughs in areas like CRISPR gene editing, personalized medicine, and synthetic biology accelerate, the complexity and volume of scientific documentation will only burgeon. This necessitates a forward-thinking approach to linguistic solutions, one that embraces technological advancements while steadfastly upholding the irreplaceable value of human linguistic and scientific expertise. The future of biotechnology translation lies in a synergistic blend of artificial intelligence and human discernment.
Machine Translation (MT) and Neural Machine Translation (NMT) are rapidly evolving, offering unprecedented speed and scalability for initial drafts of technical content. However, in the high-stakes realm of life sciences, raw MT output is rarely sufficient. The nuances of scientific terminology, the imperative for absolute accuracy, and the critical need for cultural adaptation in patient-facing materials demand meticulous human post-editing and quality assurance. Oris Translations exemplifies this hybrid approach, leveraging AI tools to enhance efficiency while ensuring that every translated document is meticulously refined by expert human linguists. This innovative integration allows for faster turnaround times and cost efficiencies without compromising the precision vital for life science professional translation services.
The increasing globalization of clinical trials and healthcare delivery further amplifies the need for robust translation capabilities. As biotech companies expand their research and market reach into diverse linguistic and cultural regions, the demand for accurate translation of patient recruitment materials, informed consent forms, patient-reported outcomes (PROs), and adverse event reports will intensify. Ensuring that patients fully understand their participation in trials and the implications of new therapies requires not just linguistic accuracy but also cultural sensitivity and an understanding of health literacy levels across various demographics. This is a critical aspect of ethical research and patient-centric healthcare.
Beyond regulatory and clinical documentation, the broader dissemination of scientific knowledge through publications, conferences, and educational materials also relies heavily on expert translation. Making groundbreaking research accessible to a global scientific community fosters collaboration, accelerates discovery, and ultimately benefits humanity. The role of health care professional translation services will continue to expand, encompassing not only the translation of highly technical documents but also the localization of marketing materials, e-learning modules, and public health campaigns to ensure that vital information reaches and resonates with diverse global audiences.
The biotechnology sector’s trajectory is undeniably global, driven by universal health challenges and the pursuit of scientific advancement. As this trajectory continues, the strategic partnership with specialized translation providers will become even more critical. These linguistic experts will not merely facilitate communication; they will actively enable innovation, ensure regulatory compliance, and ultimately contribute to the successful global deployment of life-changing biotechnological solutions. For a partner dedicated to linguistic excellence and scientific precision, explore Oris Translations’ comprehensive offerings. For a deeper dive into our specialized approach, visit our life science professional translation services page.
Culturally Sensitive Translations Ensure Patient Safety and Comprehension Worldwide.
From informed consent forms to patient education materials, our translations prioritize clarity and cultural relevance, empowering patients globally with accurate and accessible health information.
Why Choose Oris Translations for Biotechnology?
Expert Life Science Translation Services for Your Biotech Needs.
Oris Translations stands as a premier partner for biotechnology companies navigating the complexities of global communication. We understand the critical importance of accuracy, regulatory compliance, and subject matter expertise in life science translation. Our dedicated team ensures that your scientific innovations, research, and documentation are precisely conveyed across languages, maintaining their integrity and impact.
Precision. Accuracy. Expertise.
At Oris, precision is paramount. Our professional translation services guarantee that every technical term, scientific concept, and regulatory nuance is accurately translated. This meticulous approach minimizes risks and ensures compliance.
Specialist Linguists. Scientific Acumen.
Our team comprises linguists with deep scientific backgrounds. They possess not only linguistic prowess but also a profound understanding of biotechnology, ensuring the correct contextualization of your content.
Quality Assurance. Unwavering Standards.
We adhere to rigorous quality assurance protocols. Every translation undergoes multiple rounds of review and editing by senior linguists, guaranteeing the highest standards of quality and reliability.
Regulatory Compliance. Global Reach.
Navigating international regulations is complex. Oris Translations has extensive experience with regulatory documentation, ensuring your content meets the specific requirements of target markets worldwide.
Confidentiality. Data Security.
We prioritize the confidentiality and security of your sensitive information. Our robust data protection measures and strict confidentiality agreements safeguard your proprietary biotechnology data.
Timely Delivery. Project Efficiency.
We understand the fast-paced nature of the biotech industry. Our efficient project management and commitment to timely delivery ensure that your translation projects are completed on schedule, every time.
Your Gateway to New Opportunities in the Global Biotech Arena.



Our targeted translation services are designed to facilitate rapid and effective market penetration, ensuring your biotechnology products and services achieve widespread acceptance and success across diverse international markets.

Your Biotech Translation Questions Answered H3: Comprehensive Insights into Life Science Translation for Global Success.
Navigating the complexities of biotechnology translation can raise many questions. Here, we address some of the most frequently asked queries to provide clarity and demonstrate our commitment to excellence in life science professional translation services.
Regulatory Compliance
Absolute Accuracy: Navigate complex global regulations. Meticulous translation safeguards your regulatory submissions, ensuring full compliance and expedited approvals across diverse international jurisdictions, mitigating risk effectively.
Scientific Integrity
Unwavering Precision: Preserve core scientific meaning. Our expert linguists, deeply versed in life sciences, guarantee that every technical nuance and scientific detail remains perfectly intact across all languages.
Patient Safety
Clear Communication: Prioritizing patient understanding. Flawless translation of patient-facing materials ensures clarity, fostering trust and enhancing safety for diverse global populations participating in clinical trials and treatments.
Have Questions? We’re Here to Help.
Our dedicated client service team is available to provide detailed answers and guidance on our health care professional translation services. Reach out for a personalized consultation.
Ready to Transform Your Global Biotech Reach?
Connect with Oris Translations today. Our expert team is poised to discuss your specific biotechnology translation needs and craft bespoke linguistic solutions for unparalleled global success.